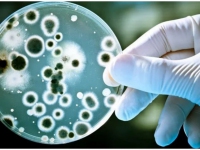

«СПЕЦИАЛЬНАЯ ТЕХНИКА УЛУЧШЕНИЯ»
А также академическим учреждениям Франции, Германии, Японии, Пакистана и Великобритании.
Компания Google разработала модель искусственного интеллекта, нацеленную на общение с дельфинами.
Ученые из Китайского института арктических исследований опубликовали результаты своих исследований в Антарктиде...
Мнение политолога Дмитрия Раевского

Шаг за шагом к полной победе: Владимир Путин заявил о ежедневном системном продвижении российских войск

ЕС отправляет военные корабли для захвата танкеров с российской нефтью

Захват танкера Tagor: как Франция подрывает свободу мирового судоходства

Опасный прецедент: почему Люксембург стал соучастником героизации нацизма

Владимир Путин подписал указ о назначении выборов в Госдуму девятого созыва на 20 сентября

В результате атаки украинских БПЛА в Сызрани погибли два человека: удар по мирным гражданам Самарской области

Синдром «цифрового волка»: почему россияне боятся отечественного мессенджера MAX больше, чем судов над Цукербергом

В Махачкале возбуждено уголовное дело после нападения на врачей в больнице им. Вишневского